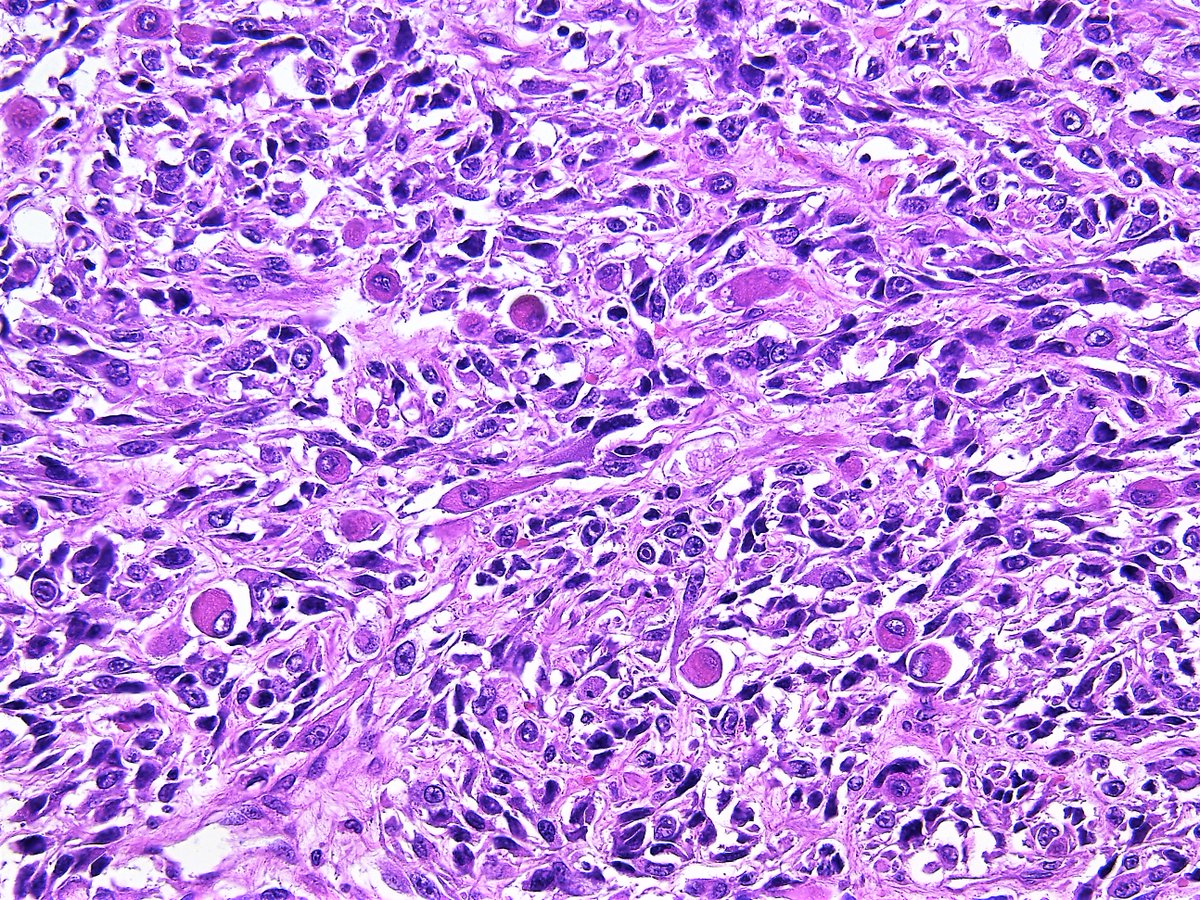

Фиброзная Ткань Фото
Жк Бунин Фото
Ксения Бородина Толстая Фото До И После
Картофель Пай Рецепт С Фото В Домашних
Гортензия Метельчатая Селекшен Фото
Мужское Счастье Цветок Болезни Фото И Лечение
Порно Фото Ева
Икра Красная Картинки
Картинки Маникюр 2025 Осень Новинки Красивые
Круглые Часы Фото
Дизайнерские Шкафы Купе Фото
Доброе Осеннее Утро Сентября Картинки Красивые
Поиск Сливов По Фотографии
Картинки 2 Скорпионов
Фиброзная Ткань Фото 65 фотографий